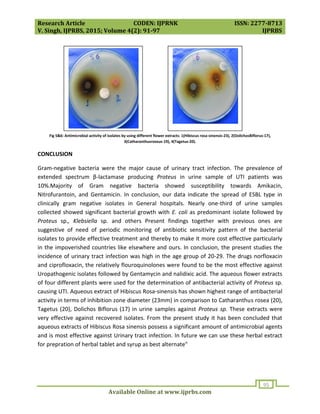
Research Article CODEN: IJPRNK ISSN: 2277-8713
V. Singh, IJPRBS, 2015; Volume 4(2): 91-97 IJPRBS
Available Online at www.ijprbs.com
95
Fig 5&6: Antimicrobial activity of isolates by using different flower extracts: 1(Hibiscus rosa-sinensis-23), 2(DolichosBiflorus-17),
3(Catharanthusroseus-19), 4(Tagetus-20).
CONCLUSION
Gram-negative bacteria were the major cause of urinary tract infection. The prevalence of
extended spectrum β-lactamase producing Proteus in urine sample of UTI patients was
10%.Majority of Gram negative bacteria showed susceptibility towards Amikacin,
Nitrofurantoin, and Gentamicin. In conclusion, our data indicate the spread of ESBL type in
clinically gram negative isolates in General hospitals. Nearly one-third of urine samples
collected showed significant bacterial growth with E. coli as predominant isolate followed by
Proteus sp., Klebsiella sp. and others Present findings together with previous ones are
suggestive of need of periodic monitoring of antibiotic sensitivity pattern of the bacterial
isolates to provide effective treatment and thereby to make it more cost effective particularly
in the impoverished countries like elsewhere and ours. In conclusion, the present studies the
incidence of urinary tract infection was high in the age group of 20-29. The drugs norfloxacin
and ciprofloxacin, the relatively flouroquinolones were found to be the most effective against
Uropathogenic isolates followed by Gentamycin and nalidixic acid. The aqueous flower extracts
of four different plants were used for the determination of antibacterial activity of Proteus sp.
causing UTI. Aqueous extract of Hibiscus Rosa-sinensis has shown highest range of antibacterial
activity in terms of inhibition zone diameter (23mm) in comparison to Catharanthus rosea (20),
Tagetus (20), Dolichos Biflorus (17) in urine samples against Proteus sp. These extracts were
very effective against recovered isolates. From the present study it has been concluded that
aqueous extracts of Hibiscus Rosa sinensis possess a significant amount of antimicrobial agents
and is most effective against Urinary tract infection. In future we can use these herbal extract
for prepration of herbal tablet and syrup as best alternate"

The study analyzed urine samples from 100 UTI patients and isolated Proteus bacteria, identifying 10 as ESBL producers. The ESBL-producing Proteus isolates were resistant to several antibiotics but sensitive to imipenem, amikacin, ciprofloxacin, and meropenem. Aqueous extracts of four plants were tested against Proteus isolates, with Hibiscus Rosa-sinensis demonstrating the highest antibacterial activity. The prevalence of ESBL-producing Proteus in urine samples was 10%, with most gram-negative bacteria sensitive to amikacin, nitrofurantoin, and gentamicin.